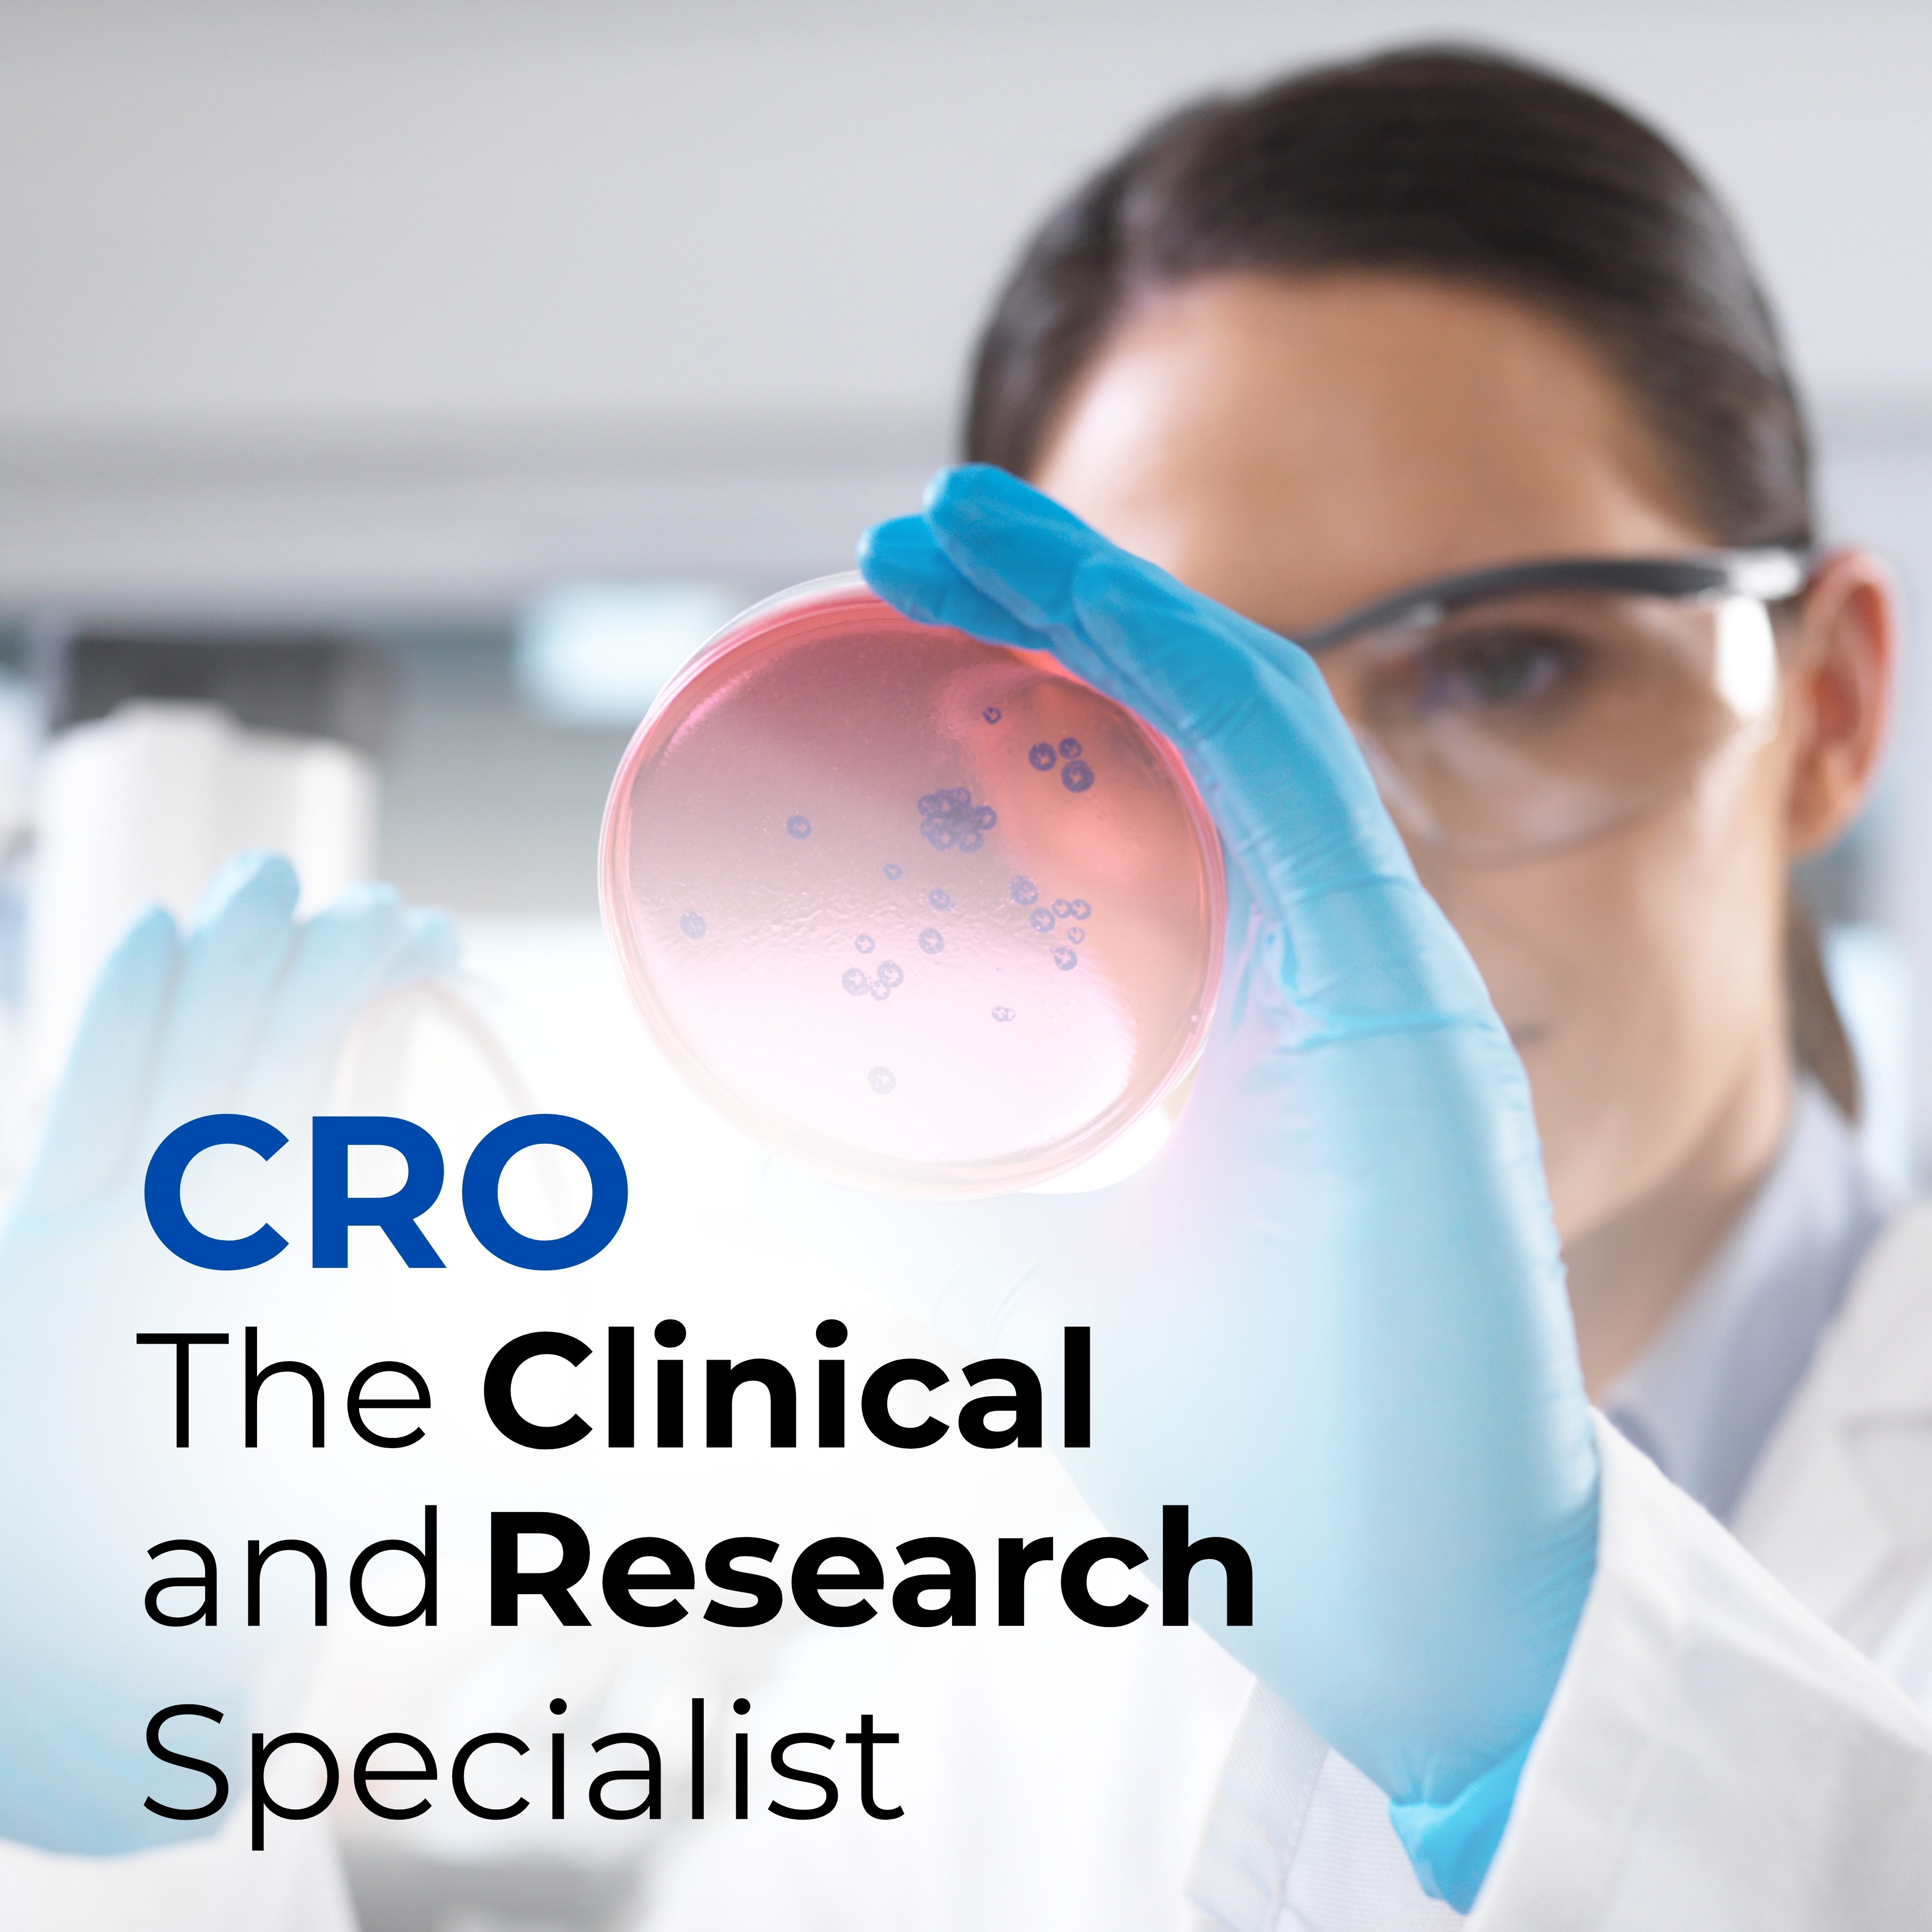

CRDMO vs CDMO vs CRO: What’s the Difference and What’s Right for You?


Understanding Pharma Outsourcing Models in 2025
Pharmaceutical outsourcing is evolving rapidly, and so is the language used to describe it. Acronyms like CRO, CDMO, and now CRDMO are commonly seen across the pharma industry, but what do they mean? More importantly, which model is the right fit for your molecule’s journey?
In this blog, we break down the differences, benefits, and ideal use cases for each and explain why the CRDMO model is emerging as the preferred partner structure for companies seeking integrated, efficient, and compliant development.
What Is a CRO, CDMO, and CRDMO?
|
Term |
Full Form |
Primary Function |
|
CRO |
Contract Research Organization |
Focuses on research, clinical trials, and regulatory affairs |
|
CDMO |
Contract Development & Manufacturing Org. |
Handles formulation, scale-up, and manufacturing |
|
CRDMO |
Contract Research, Development & Manufacturing Org. |
Combines both CRO + CDMO under one umbrella |
CRO: The Clinical and Research Specialist
Contract Research Organizations (CROs) offer preclinical and clinical trial management services, regulatory strategy, and data analysis. They’re ideal for:
- Early-stage drug discovery
- Managing complex clinical trials
- Regulatory dossier preparation
However, CROs typically do not support formulation, scale-up, or manufacturing, which means innovators must eventually transition to a CDMO
CRDMO Outsourcing for Pharma Development: A Strategic and Technical Perspective
CDMO: The Scale-Up and Production Partner
Contract Development and Manufacturing Organizations (CDMOs) specialize in later-stage development:
- Formulation and analytical method development
- Tech transfer and process validation
- GMP manufacturing and packaging
But CDMOs often don’t engage in research or clinical services, resulting in gaps during early-stage development and longer timelines due to handovers.

CRDMO: The End-to-End Innovation Engine
Contract Research, Development, and Manufacturing Organizations (CRDMOs) like Pharmaffiliates solve this fragmentation. By integrating research, analytics, regulatory, and manufacturing, CRDMOs allow pharmaceutical companies to streamline:
- Early-stage discovery
- Impurity profiling & analytical development
- GMP scale-up and batch release
- Regulatory documentation and submissions
Which Model Is Right for You?
|
Need |
Best Fit |
|
Molecule/ Impurity research |
CRO |
|
Manufacturing scale-up only |
CDMO |
|
Full lifecycle from lab to launch |
CRDMO |
|
Streamlined compliance documentation |
CRDMO (GMP + CMC) |
|
Reduced cost and faster timelines |
CRDMO (Integrated) |
For molecule innovators looking to reduce fragmentation, avoid data transfer issues, and gain regulatory-ready documentation, CRDMOs offer unmatched efficiency.

Why Pharmaffiliates as Your CRDMO Partner?
With over 20 years in impurity reference standards, ISO 17025-accredited labs, and GMP-certified manufacturing units, Pharmaffiliates provides:
- End-to-end CRDMO services under one compliant system
- Faster transitions from research to production
- Global regulatory alignment (USFDA, ICH, WHO-GMP)
- CMC documentation, method validation, and lifecycle management
Conclusion: Choose an Integrated Future
In 2025 and beyond, pharma success requires speed, compliance, and data continuity. CROs and CDMOs may fulfil isolated needs, but only a CRDMO model enables a holistic, efficient path to market.
Pharmaffiliates stands as your trusted CRDMO partner to accelerate development, maintain quality, and simplify regulatory journeys.
Frequently Asked Questions (FAQ)
What is the difference between a CRO, CDMO, and CRDMO? A CRO handles research and clinical services. A CDMO focuses on manufacturing. A CRDMO brings both aspects together to provide comprehensive pharmaceutical development services.
Is CRDMO the future of pharma outsourcing? Yes. CRDMOs like Pharmaffiliates are emerging as preferred partners due to integrated services, reduced handover risk, and compliance alignment.
Does Pharmaffiliates provide both CRO and CDMO services? Yes, under the CRDMO model, including analytical method development, GMP manufacturing, and regulatory documentation.





